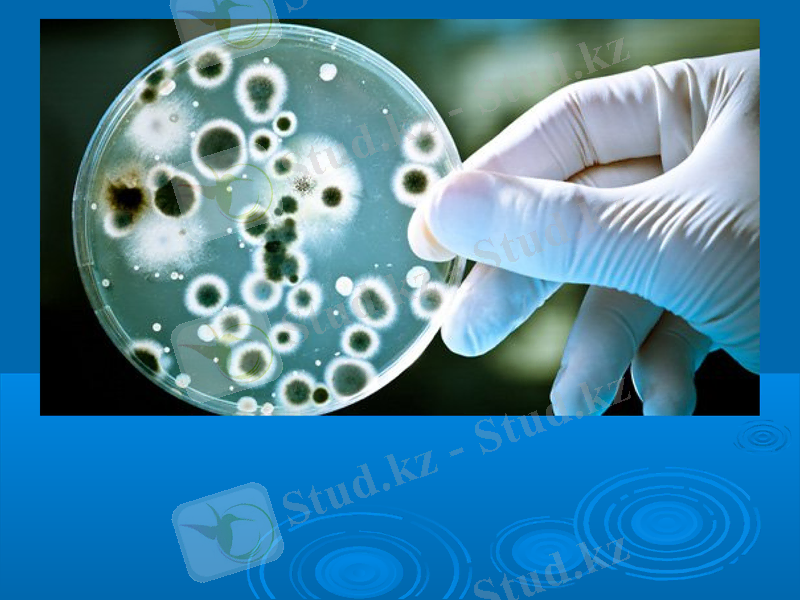
Slide 5

Бруцеллез (сарып): этиология, клиника, диагностика және емдеу



Бруцеллез
Орындаған: Мұратбекова Ақбота
ВС-403

Сарып
І. Сарып - зоонозды инфекциялық аллергиялық, көбіне созылмалы түрге бейім, қызба, әлсіздік, тершеңдік белгілерімен, сүйек-буын, жүйке, ішкі ағзалар, несеп-жыныс жүйелерін зақымдайтын жұқпалы дерт. Қоздырғышы - brucellae туыстығына жататын, ұсақ, таяқша немесе кокк тәрізді, қозғалмайтын, спора түзбейтін, анилиндік бояулармен жақсы боялатын, эндотоксин бөлетін бактериялар. Бруцеллалар сыртқы ортада өте шыдамды болып келеді: малдың тезегінде, зәрінде, мал ластаған суда 40 күнге дейін «өлмей» өмір сүреді; мұзға, қарға түскен бруцеллалар 1-2 айға дейін шыдайды; топырақ қыртысында, көңде, қида 3-4 ай өмір сүреді. Бруцеллалар күннің тура түскен сәулесі мен қайнатуға сезімтал болады.

Сарып ауруы үш түрлі жолмен жұғуы мүмкін: · Тағамдар (элиментарлық) арқылы, · Тұрмыстық қарым-қатынас кезінде, · Аэрогенді жолмен. Сарыптың жасырын кезеңі- 3-4 апта. Эндемиялық аймақтарда сатып антигеніне сенсибилизацияланған адамдарда жасырын мерзім 2, 5 ай және одан да ұзақ болуы мүмкін.

Жедел сарып диагнозы ауру ағымының ұзақтығы 3 айға дейін созылғанда қойылады. Клиникалық көріністері уытты сепсистік процестермен байқалады. Ауру басталғанда науқаста жоғары толқын тәрізді, интермиттірлік және дұрыс емес типтегі қызба болады. Дене қызуы 39-40 градусқа дейін көтерілгеніне қарамай сарыпқа шалдыққан науқастың жалпы жағдайы нашарламайды. Қызбамен қатар науқас адам қатты терлейді, буын ауырып, сүйектері сырқырайды, ұйқысы бұзылып, басы ауырады. Аймақтық лимфа бездерінің, бауыр мен көк бауырдың ұлғайғаны, гипотония, брадикардия, жүре, к тондарының тұйықталуы анықталады.

Ем науқаста сарыптың клиникалық белгілері болған кезде тағайындалады. Сарыптың жедел, жеделдеу түрлерінде төменде көрсетілген емді қолданған дұрыс:
- антибактериальдық ем,
- дезонтоксикациялық ем,
- қабынуға қарсы дәрі-дәрмектер,
- иммуномодуляторлар.
Ал аурудың созылмалы түрлерінде тағайындалатын ем:
- гипосенсибилизациялық ем,

Ауру ауадағы шаң арқылы жұққанда респираторлы синдромның белгілерімен басталуы мүмкін. Сондай-ақ бронхтардың қабынуы, түбірлік өкпе қабынуы, жедел тонзиллит, перитонзиллярлы абцесс, экссудативті плеврит сияқты өзгерістер де кездеседі. Өте сирек кездесетін жағдай - бұл құрт тәрізді өсіндіде қабыну процесінің болуы (жедел аппендицит)
Шеткі қан анализінде лейкопения, салыстырмалы лимфоцитоз, эритроциттердің тұну жылдамдығының қалыпты немесе бірыңғай жылдамдауы байқалады. Улану белгілеріне байланысты науқастардың зәрінде альбуминурия, микрогематурия сияқты өзгерістер байқалады. Сарып диагнозын дұрыс қою үшін науқасты толық және мұқият тексере білу керек:ұрыс қою үшін науқасты толық және мұқият тексере білу керек: Лабораториялық зерттеу әдістері: бактериологиялық, биологиялық, серологиялық, аллергологиялық. Сарыпқа қарсы емдеу аурудың түріне, клиникалық белгілеріне, әсіресе ошақты зақымданулар сипатына, қосалқы басқа ауруларға, тағайындалатын дәрілерге бейімділігіне және тағы басқаларға байланысты болады.




Назарларыңызға рахмет!!!
- Іс жүргізу
- Автоматтандыру, Техника
- Алғашқы әскери дайындық
- Астрономия
- Ауыл шаруашылығы
- Банк ісі
- Бизнесті бағалау
- Биология
- Бухгалтерлік іс
- Валеология
- Ветеринария
- География
- Геология, Геофизика, Геодезия
- Дін
- Ет, сүт, шарап өнімдері
- Жалпы тарих
- Жер кадастрі, Жылжымайтын мүлік
- Журналистика
- Информатика
- Кеден ісі
- Маркетинг
- Математика, Геометрия
- Медицина
- Мемлекеттік басқару
- Менеджмент
- Мұнай, Газ
- Мұрағат ісі
- Мәдениеттану
- ОБЖ (Основы безопасности жизнедеятельности)
- Педагогика
- Полиграфия
- Психология
- Салық
- Саясаттану
- Сақтандыру
- Сертификаттау, стандарттау
- Социология, Демография
- Спорт
- Статистика
- Тілтану, Филология
- Тарихи тұлғалар
- Тау-кен ісі
- Транспорт
- Туризм
- Физика
- Философия
- Халықаралық қатынастар
- Химия
- Экология, Қоршаған ортаны қорғау
- Экономика
- Экономикалық география
- Электротехника
- Қазақстан тарихы
- Қаржы
- Құрылыс
- Құқық, Криминалистика
- Әдебиет
- Өнер, музыка
- Өнеркәсіп, Өндіріс
Қазақ тілінде жазылған рефераттар, курстық жұмыстар, дипломдық жұмыстар бойынша біздің қор #1 болып табылады.



Ақпарат
Қосымша
Email: info@stud.kz